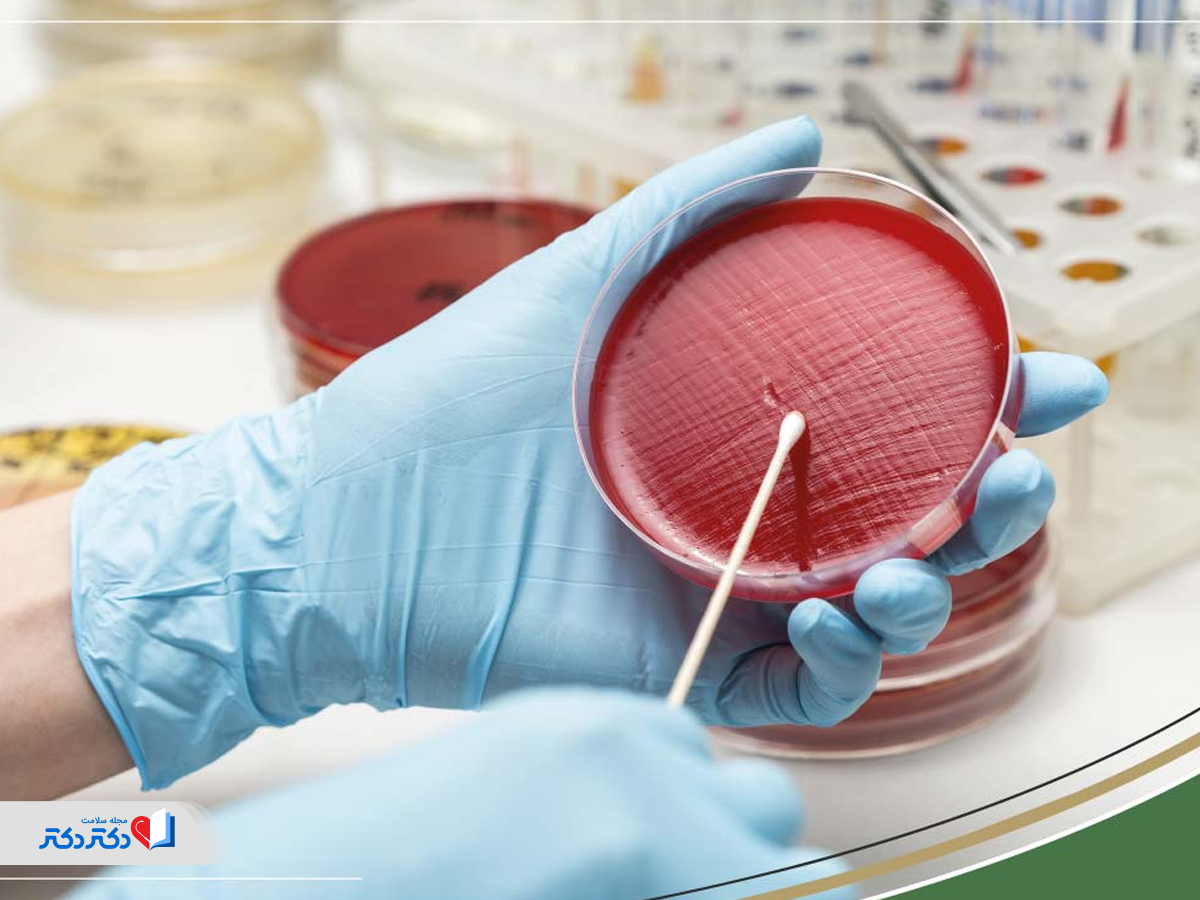
کشت ادرار برای بررسی میکروب

برای یافتن علت بسیاری از بیماریها از آزمایشهای گوناگونی مانند آزمایش خون، ادرار و مدفوع استفاده میشود. هر یک از این آزمایشها اطلاعات و پارامترهای متفاوت و خاصی را در مورد بدن انسان نشان میدهند و به پزشکان در شناسایی و درمان انواع مختلف اختلالها و بیماریها کمک میکنند. بهعنوان مثال کاربرد اصلی آزمایش ادرار در تشخیص عفونتها، مشکلات کلیوی، بارداری و دیابت است. با بررسی مواردی مانند غلظت، رنگ و بوی ادرار، میتوان اطلاعات زیادی درباره سلامت بدن بدست آورد. از این جهت داشتن دانش کافی و آشنایی با علائم اختصاری در برگه آزمایش ادرار، به شما کمک میکند تا بتوانید بهتر و با دقت بیشتری آزمایش خود را قبل از کمک گرفتن از پزشک ارزیابی کنید. ما در این مقاله تصمیم داریم بهطور کامل درباره تفسیر آزمایش ادرار برای شما توضیح دهیم. همراه ما باشید.
آزمایش ادرار ۲۴ساعته چیست؟
آزمایش ادرار ۲۴ساعته یک رویکرد دقیق پزشکی برای سنجش عملکرد کلیهها و میزان دفع پروتئین، کلسیم، کراتینین و هورمونها در طول شبانهروز است. این تست نوسان غلظت محتویات خون را در طول ۲۴ ساعت به پزشک نمایش میدهد تا علائم نارسایی کلیوی، دیابت، سنگ کلیه و مسمومیت حاملگی را تشخیص دهد.
اهداف اصلی از تجویز آزمایش ادرار اورژانسی عبارتاند از:
- ارزیابی عملکرد کلیه: اندازهگیری دقیق کراتینین و سنجش میزان تصفیه خون توسط کلیهها؛
- بررسی دفع پروتئین: تشخیص بیماریهای کلیوی، دیابت کلیوی یا مسمومیت حاملگی؛
- ریشهیابی سنگ کلیه: اندازهگیری کلسیم، اگزالات، اسید اوریک و سیترات برای پیشگیری از تشکیل مجدد سنگ؛
- بررسی اختلالات هورمونی: تشخیص بیماریهای سندرم کوشینگ یا تومورهای خاص (مانند فئوکروموسیتوم).

آزمایش ادرار (UA) برای تشخیص چه بیماریهایی گرفته میشود؟
آزمایش ادرار برای ارزیابی و شناسایی علت بسیاری از بیماریها و اختلالها کاربرد دارد. وجود برخی مشکلات در اندامهایی مانند کلیه، مجاری ادراری و مثانه، کبد و ریهها روی عملکرد کلیهها و فرایند دفع اثر میگذارد؛ به همین دلیل آزمایش ادرار میتواند در شناسایی این مشکلات مفید باشد.
در بیشتر موارد تست ادرار در کنار بقیه آزمایشها تجویز میشود. بهعنوان مثال برای تشخیص بیماریهای دیابت، مشکلات کلیوی، کبدی و عفونتهای مجاری ادراری و همچنین بررسی دلیل وجود علائمی مثل دردهای شکمی، وجود خون در ادرار، احساس سوزش هنگام ادرار و درد کمر از آزمایش ادرار استفاده میشود. بررسی محتوای ادرار، رنگ، بو، شفافیت، وزن و میزان اسیدی بودن آن در تشخیص علت اختلال و پیدا کردن درمان آن موثر است. همچنین برای تست اعتیاد و بارداری نیز آزمایش ادرار تجویز میشود.
فرق کشت ادرار با آزمایش ادرار چیست؟
آزمایش ادرار ناشتا و آزمایش کشت ادرار متفاوتاند، اولی بهدنبال تغییرات ظاهری در اجزاء ادرار میگردد و دیگری بهدنبال عامل عفونت.
تست ادرار یک بررسی کلی و سریع برای سنجش ویژگیهای فیزیکی و شیمیایی ادرار است. در این تست، تکنسین از نوارها و میکروسکوپ استفاده میکند تا تغییرات رنگ، بو، pH، وجود قند، پروتئین، گلبولهای سفید و قرمز را بررسی کند. پزشک با خواندن نتایج این تست میفهمد که آیا التهاب یا مشکلی در کلیهها هست یا نه، اما از نوع دقیق باکتری باخبر نمیشود.
کشت ادرار در صورتی تجویز میشود که پزشک در نتایج تست ادرار عفونت مشکوک پیدا کند. در این آزمایش، نمونه ادرار بهمدت ۲۴ الی ۴۸ ساعت در یک محیط مغذی آزمایشگاهی قرار میگیرد تا باکتری یا قارچ احتمالی فرصت رشد پیدا کند. پساز رشد میکروب، تستی به نام آنتیبیوگرام روی آن انجام میشود تا نوع میکروب و آنتیبیوتیک مؤثر برای درمان آن شناسایی شود.

چگونه آزمایش ادرار گرفته میشود؟
برای انجام آزمایش ادرار ابتدا لازم است که شما از آزمایشگاه ظرفهای پلاستیکی مخصوص نمونهگیری را تهیه کنید و بعد در داخل خانه یا آزمایشگاه نمونه ادرار خود را در آن بریزید. برای اینکه نتیجه آزمایش شما دقیق باشد بهتر است به نکات زیر توجه کنید:
- قبل از رفتن به آزمایشگاه ۱ یا ۲ لیوان آب بخورید تا بتوانید بهمقدار کافی نمونه ادرار جمعآوری کنید.
- دستهای خود را بهخوبی بشویید و از لمس بخش داخلی ظرف نمونهگیری امتناع کنید.
- قبل از جمعآوری نمونه، ناحیه تناسلی خود را بشویید و خشک کنید.
- برای آزمایش ادرار لازم نیست که ناشتا باشید؛ مگر اینکه بخواهید همزمان آزمایشهای دیگری نیز بدهید.
- قبل از انجام آزمایش، پزشک و مسئول آزمایشگاه را درباره داروهایی که مصرف میکنید مطلع کنید. زیرا برخی داروها مثل مکملهای ویتامین C، آنتیبیوتیکها، ریبوفلاوین، مترونیدازول، متوکاربامول و آنتراكینون روی نتیجه آزمایش اثر میگذارد.
- برای نمونهگیری ادرار، بهتر است اول صبح این کار انجام شده و از وسط ادرار نمونه جمعآوری شود.
- بعد از نمونهگیری، ظرف را داخل محفظههای مشخص در سرویس بهداشتی آزمایشگاه قرار دهید. در صورتی که در خانه هستید، میتوانید آن را حداکثر تا ۸ ساعت در یخچال نگهداری کنید.
نحوه جمعآوری نمونه ادرار
برای دستیابی به نتایج دقیق، اولین ادرار صبحگاهی را دور بریزید و تا ۲۴ ساعت بعد، تمامی دفعات ادرار را در ظرف مخصوصی که آزمایشگاه در اختیارتان میگذارد، جمعآوری کنید. این ظرف باید در محیط خنک یخچال نگهداری شود. حواستان باشد، تا ۲۴ ساعت آینده هیچ نوبت ادراری نباید از دست برود؛ چراکه حتی حذف یک نمونه کوچک نتیجه نهایی را بهکل تغییر میدهد.
برای جلوگیری از ورود باکتریهای محیطی به نمونه ادرار، ابتدا دستها و ناحیه تناسلی را با آب تمیز و خشک کنید. سپس اجازه دهید بخش اول ادرار تخلیه و مجاری ادراری شسته شود، سپس بیآنکه جریان ادرار را متوقف کنید، حدود ۳۰ تا ۶۰ میلیلیتر را در ظرف استریل جمعآوری و باقیمانده را مجددا تخلیه کنید.

تفسیر کامل آزمایش ادرار
در آزمایش ادرار ویژگیهای فیزیکی، شیمیایی و میکروسکوپی ادرار بررسی میشود. تفسیر آزمایش ادرار بسیار مهم است و باید توسط متخصص انجام شود. شما با نشان دادن نتایج آزمایش ادرار خود به یکی از متخصصان اورولوژی شهرتان، به اطلاعات تخصصیتر و دقیقتری دست خواهید یافت. خوشبختانه، در تمام شهرهای ایران، چندین متخصص اورولوژی خوب و باتجربه در حال فعالیت هستند که شما میتوانید از خدمات تخصصی آنها بهرهمند شوید. برای مثال اگر ساکن تهران هستید، با یافتن بهترین دکتر کلیه تهران میتوانید از متخصص مورد نظر خود نوبت گرفته و برای تفسیر آزمایش ادرار و قرار گرفتن در روند درمانی به او مراجعه کنید.
معنی نگاتیو (negative) در آزمایش ادرار چیست؟
کلمه «Negative» یا «منفی» در آزمایش ادرار یعنی ماده مورد بررسی (خون، پروتئین، قند، نیتریت یا کتون) در ادرار یافت نشده و مقدار آن در محدودۀ طبیعی و سالم قرار دارد. به زبان سادهتر، منفیبودن این شاخصها بیانگر نبود نشانههای بیماری، عفونت یا اختلال در سیستم ادراری و کلیههاست. از نظر پزشکی، نتیجۀ منفی تست ادرار مطلوب محسوب میشود.
بررسی خصوصیات فیزیکی ادرار
در تفسیر آزمایش ادرار، خصوصیات فیزیکی شامل رنگ، وزن، شفافیت و میزان اسیدی بودن (PH) ادرار است.
رنگ طبیعی ادرار
رنگ طبیعی ادرار زرد کمرنگ تا کهربایی تیره است و بهدلیل وجود رنگدانهای به نام Urochrome، این رنگها ایجاد میشود. بسته به نوع تغذیه و غلظت ادرار، رنگ آن نیز تغییر میکند. هرچه آب بیشتری مصرف شود، ادرار رقیقتر و رنگ آن روشنتر میشود. بهطور کلی مواد غذایی مانند چغندر و لوبیا، داروها، مصرف مایعات و عفونت ادراری رنگ ادرار را تغییر میدهد.
میزان شفافیت ادرار
ادرار بهصورت طبیعی شفاف است؛ ولی عواملی مثل مواد غذایی چرب، عفونتهای ادراری، انگل، قارچ، اسپرم و گلوبولهای قرمز و سفید خون موجب تغییر شفافیت ادرار میشود.
وزن ادرار
وزن ادرار شامل مواد دفعی و املاح موجود در ادرار است. هرگاه ادرار بهدلیل وجود مشکلاتی مثل اسهال، استفراغ و تب بالا غلیظ شود، وزن آن نیز بالا میرود؛ در حالی که برخی بیماریهای کلیوی، مصرف زیاد مایعات و دیابت بیمزه، میتواند وزن ادرار را کاهش دهد.
PH یا اسیدیته ادرار
عدد PH طبیعی ادرار بین ۶/۴ تا ۸ است. تعیین میزان اسیدی بودن ادرار در شناسایی سنگهای کلیه موثر است. مشکلاتی مانند دیابت و اسهال PH را بالا میبرد و همچنین عفونتهای مجاری ادرای و استفراغ موجب کاهش PH ادرار میشود.

بررسی ویژگیهای شیمیایی ادرار
ویژگیهای شیمیایی ادرار شامل بررسی پروتئین، گلوکز و اجسام کتونی در ادرار است.
پروتئین ادرار
در حالت طبیعی در ادرار نباید پروتئین وجود داشته باشد. التبه عواملی مثل ورزش شدید، بارداری و تب میتواند روی مقدار این پارامتر اندکی تاثیر بگذارد. در حالت کلی اگر میزان پروتئین ادرار بالا باشد، احتمال وجود بیماریهای کلیوی، عفونت مجاری ادراری، فشار خون بالا و دیابت افزایش مییابد.
گلوکز ادرار
مانند پروتئین، در ادرار گلوکز نیز نباید وجود داشته باشد، مگر اینکه وجود بیماریهای کلیوی و دیابت شیرین باعث افزایش قند یا گلوکز ادرار شده باشد.
اجسام کتونی در ادرار
در فرایند سوختوساز بدن، زمانی که چربیها مصرف شده و تبدیل به انرژی میشوند، کتونها به وجود میآیند و ممکن است در ادرار ترشح شوند. در حالت طبیعی نباید در ادرار کتونی وجود داشته باشد. اگر مقدار کتون در ادرار بالا رود، نشاندهنده وجود بیماریهای کلیوی، دیابت کنترلنشده، مصرف زیاد الکل، بیماری آنورکسیا، استفراغ و تب شدید است.
یکی از بیماریهایی که برای تشخیص آن به آزمایش ادرار نیاز است عفونت بیمارستانی است. برای آشنایی با این بیماری مقاله علائم عفونت بیمارستانی را بخوانید.
در آزمایش میکروسکوپی ادرار، با بررسی قطرات ادرار توسط میکروسکوپ وجود مشکلاتی مثل تومور، عفونتهای مجاری ادراری، مشکلات کلیوی، سنگ کلیه و سرطان مثانه بررسی میشود.

آزمایش ادرار چه بیماریهایی را مشخص میکند؟
بهطورکلی آزمایش ادرار در تشخیص بیماریهای مربوط به کلیه، مجاری ادراری، کبد و دیابت کاربرد دارد. با بررسی ویژگی و کیفیت ادرار میتوان درباره وجود اختلال در بدن اطلاعاتی کسب کرد. در ادامه به برخی از این موارد اشاره میکنیم.
- اگر خون در آزمایش ادرار وجود داشته باشد، احتمال ابتلا به عفونتهای مجاری ادراری افزایش مییابد. درصورتیکه این مشکل مدتزمان زیادی طول بکشد، ممکن است بیمار به سرطان مثانه یا پروستات مبتلا باشد. در برگه آزمایش وجود خون در ادرار را با RBC نشان میدهند. اگر میزان خون در ادرار زیاد باشد، بهصورت RBC مثبت بیان میشود که نیاز به تشخیص و درمان دارد. در حالت کلی وجود خون در ادرار مسئلهای طبیعی نیست؛ اما موضوعی بهشدت نگرانکننده هم تلقی نمیشود.
- در حالت طبیعی ادرار باید شفاف و رنگ آن زرد کمرنگ تا کهربایی تیره باشد. در غیر این صورت احتمالا عفونت مجاری ادراری، انگل یا قارچ در بدن وجود دارد. با بررسی رنگ و شفافیت ادرار میتوان درستی این موضوع را بررسی کرد.
- با بررسی بو ادرار میتوان برخی بیماریها مثل دیابت، عفونت کلیهها، مثانه و همچنین نارسایی کلیوی را تشخیص داد.
- اگر میزان پروتئین در ادرار بالا باشد، ممکن است فرد مبتلا به بیماری کلیوی، دیابت یا فشارخون بالا باشد. در حالت طبیعی نباید در ادرار پروتئینی وجود داشته باشد. در غیر این صورت، احتمال ابتلا به بیماری پروتئینوری وجود خواهد داشت. در این بیماری که نوعی آسیب کلیوی است، کلیه فرد بیمار نمیتواند پروتئینهای موجود در کلیه را خارج کند و در بدن باقی میمانند. عواملی مثل استرس، ورزش، تب و مصرف آسپیرین در ایجاد این بیماری نقش دارند.
- ادرار در حالت طبیعی کمی اسیدی است و PH آن در حدود ۶ است. اما این عدد میتواند بین ۵/۴ تا ۸ متغیر باشد. اگر ادرار بیشازحد اسیدی شود، احتمال تولید سنگ کلیه بالا میرود. همچنین در صورتی کهPH ادرار افزایش یابد، میتواند نشاندهنده وجود دیابت یا اسهال باشد و اگر این عدد از مقدار طبیعی کمتر باشد، احتمال عفونتهای ادراری و استفراغ نیز افزایش مییابد.
- وجود کف یا خون در ادرار نشاندهنده بیماری گلومرولونفریت است که نوعی اختلال در کلیهها است. این بیماری موجب نارسایی کبدی، تجمع آب زیرپوستی و افزایش فشارخون میشود.
- وجود گلوکز در ادرار نشاندهنده ابتلا به دیابت شیرین یا نوعی بیماری کلیوی است. بهطور طبیعی نباید هیچگونه قند یا گلوکزی در ادرار وجود داشته باشد. معمولا تغییرات هورمونی، بیماریهای مربوط به کبد و کلیهها، مصرف برخی داروها و بارداری موجب افزایش سطح گلوکز ادرار میشوند. ممکن است برای تشخیص دیابت آزمایش خون نیز تجویز شود.
- مقدار کتون در ادرار یک فرد سالم باید صفر باشد. کتونها زمانی در بدن تولید میشوند که گلوکز کافی برای تولید انرژی در دسترس سلولهای بدن نباشد و نوعی محصول متوسط متابولیسم چربی هستند. اگر مقدار کتون در ادرار افزایش یابد، ممکن است بیمار به آنورکسیا، دیابت کنترل نشده یا اختلال کلیوی مبتلا باشد. در دیابت کنترل نشده یا دیابت نوع یک، معمولا افزایش کتون نشاندهنده ترشح انسولین ناکافی است. عواملی مثل ورزش شدید، استفراغ طولانیمدت، بیماریهای گوارشی و قرار گرفتن در محیط سرد میتواند در تولید کتون در بدن نقش داشته باشد.
- با بررسی میزان کلسیم و برخی اسیدهای موجود در ادرار، میتوان وجود سنگ کلیه را بررسی کرد.

تفسیر آزمایش کشت ادرار
آزمایش کشت ادرار (UC) برای تشخیص احتمال ابتلا به عفونت ادراری تجویز میشود. در صورتی که باکتری یا مخمر وارد مجاری ادراری شود، منجر به ایجاد عفونت شده که اگر بهموقع درمان نشود احتمال بروز بیماریهای کلیوی و امکان ورود عفونت به خون افرایش مییابد.
در آزمایش کشت ادرار، بخشی از ادرار را در محیطی قرار میدهند که باکتریها بتوانند بهخوبی رشد کنند و از همین طریق میتوان از وجود و حجم عفونت اطلاعاتی کسب کرد. در تفسیر این آزمایش اگر مقدار باکتری موجود بیشتر از ۱۰۰ هزار کلونی باشد، جواب تست مثبت اعلام میشود.
تفسیر و بررسی علائم اختصاری در برگه آزمایش ادرار
در این قسمت در مورد علائم اختصاری موجود در برگه آزمایش ادرار توضیح میدهیم.
- رنگ: رنگ ادرار را با موارد زیر تعیین میکنند. همان طور که گفتیم، رنگ طبیعی ادرار زرد کمرنگ تا کهربایی تیره است.
- شفافیت: ادرار در حالت طبیعی باید شفاف باشد.
- بو: ادرار در حالت طبیعی نباید بو داشته باشد و در صورت وجود بو غیرطبیعی احتمال وجود عفونت ادراری افزایش مییابد.
- وزن ادرار: محدوده طبیعی وزن ادرار در حدود ۱٫۳ تا ۱٫۵۳ است.
- PH: همان طور که اشاره کردیم، بازه طبیعی میزان اسیدی بودن ادرار در حدود ۶/۴ تا ۸ است.
- پروتئین: محدوده طبیعی مقدار پروتئین موجود در ادرار بین ۵۰ تا ۸۰ میلیگرم است.
- گلوکز: در حالت طبیعی نباید در ادرار گلوکز وجود داشته باشد.
- کتون: مقدار کتون نیز در حالت طبیعی باید صفر باشد.
- کریستال: در صورت نبود عفونت یا بیماری، مقدار کریستال در ادرار باید کم باشد یا اصلا وجود نداشته باشد.
- گلبولهای سفید و قرمز خون (WBC و RBC): در حالت طبیعی نباید گلبولهای قرمز و سفید در ادرار وجود داشته باشد و مقدار این پارامترها باید صفر باشد.
- وجود خون در ادرار: معنی Trace در آزمایش ادرار بهمعنای وجود خون در ادرار است. وجود خون میتواند نشانه وجود عفونتهای مجاری ادراری باشد.
کلام آخر دکتردکتر!
آزمایش ادرار یکی از سریعترین و ارزانترین راهها برای بررسی سلامت داخلی بدن است که میتواند پیش از بروز علائم شدید، از وضعیت کلیهها، کبد و سیستم ایمنی شما خبر دهد. این تست همانند آزمایشهای خون و مدفوع برای تشخیص بیماریهای گوناگون مثل عفونت، دیابت، مشکلات مجاری ادراری کاربرد دارد و همچنین برای تشخیص اعتیاد و بارداری تجویز میشود. تغییرات غیرطبیعی در رنگ و بوی ادرار را در جلسات گفتوگوی آنلاین دکتردکتر با متخصصان باتجربه در میان بگذارید تا درصورت نیاز، نسخه آزمایش را برایتان بنویسند.
برای آنکه نتیجه دقیق و قابل اعتماد باشد، رعایت بهداشت در زمان نمونهگیری و انتقال سریع نمونه به آزمایشگاه بسیار کلیدی است. اگر فرصت کافی ندارید، از خدمات آزمایش در محل دکتردکتر استفاده کنید و تفسیر نهایی را به پزشکان متخصص ما بسپارید.
منابع:









در خصوص نتایج میکروسکوپی مطلبی نداشتید